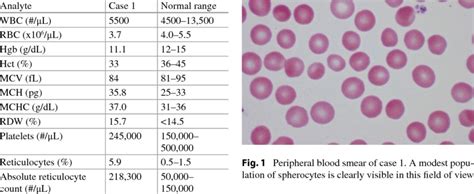
Complete Blood Count And Reticulocyte Count Of Case 1 Download Table

Low Reticulocyte Count
A low reticulocyte count is a medical condition characterized by an abnormally low number of reticulocytes in the blood. Reticulocytes are immature red blood cells that are produced in the bone marrow and released into the bloodstream, where they mature into adult red blood cells. A normal reticulocyte count ranges from 0.5% to 1.5% of the total red blood cell count, but this can vary depending on the individual and the laboratory conducting the test.
To understand the significance of a low reticulocyte count, it’s essential to first comprehend the role of reticulocytes in the body. Reticulocytes are a crucial component of the blood, responsible for carrying oxygen to the body’s tissues. When the bone marrow produces red blood cells, it first creates reticulocytes, which then mature into adult red blood cells. A low reticulocyte count can indicate a problem with the production of red blood cells in the bone marrow, which can lead to anemia and other blood-related disorders.
There are several possible causes of a low reticulocyte count, including bone marrow failure, anemia, and blood cell disorders. Bone marrow failure occurs when the bone marrow is unable to produce enough blood cells, leading to a decrease in the production of reticulocytes. Anemia, on the other hand, is a condition characterized by a decrease in the number of red blood cells or the amount of hemoglobin in the blood. Blood cell disorders, such as leukemia or lymphoma, can also affect the production of reticulocytes.
Causes of Low Reticulocyte Count

- Bone Marrow Failure: Bone marrow failure occurs when the bone marrow is unable to produce enough blood cells, leading to a decrease in the production of reticulocytes. This can be caused by various factors, including bone marrow disorders, radiation therapy, and certain medications.
- Anemia: Anemia is a condition characterized by a decrease in the number of red blood cells or the amount of hemoglobin in the blood. There are several types of anemia, including iron deficiency anemia, vitamin deficiency anemia, and anemia of chronic disease.
- Blood Cell Disorders: Blood cell disorders, such as leukemia or lymphoma, can affect the production of reticulocytes. These disorders can cause the bone marrow to produce abnormal blood cells, leading to a decrease in the production of reticulocytes.
- Infection: Certain infections, such as viral or bacterial infections, can affect the production of reticulocytes. These infections can cause the bone marrow to produce fewer reticulocytes, leading to a low reticulocyte count.
- Medications: Certain medications, such as chemotherapy and radiation therapy, can affect the production of reticulocytes. These medications can cause the bone marrow to produce fewer reticulocytes, leading to a low reticulocyte count.
Symptoms of Low Reticulocyte Count
The symptoms of a low reticulocyte count can vary depending on the underlying cause, but common symptoms include:
- Fatigue: Fatigue is a common symptom of a low reticulocyte count, as the body may not have enough red blood cells to carry oxygen to the tissues.
- Weakness: Weakness is another common symptom of a low reticulocyte count, as the body may not have enough red blood cells to carry oxygen to the muscles.
- Shortness of Breath: Shortness of breath is a symptom of a low reticulocyte count, as the body may not have enough red blood cells to carry oxygen to the lungs.
- Pale Skin: Pale skin is a symptom of a low reticulocyte count, as the body may not have enough red blood cells to carry oxygen to the skin.
- Headaches: Headaches are a symptom of a low reticulocyte count, as the body may not have enough red blood cells to carry oxygen to the brain.
Diagnosing a Low Reticulocyte Count
- Consult with a healthcare professional to determine the underlying cause of the low reticulocyte count.
- Undergo a physical examination to check for any signs of anemia or other blood-related disorders.
- Provide a complete medical history, including any previous illnesses or medications.
- Undergo a blood test to measure the reticulocyte count and other blood cell counts.
- Undergo imaging tests, such as a bone marrow biopsy, to check for any abnormalities in the bone marrow.
Treatment Options for Low Reticulocyte Count
The treatment options for a low reticulocyte count depend on the underlying cause, but common treatment options include:
- Blood Transfusions: Blood transfusions may be necessary to increase the number of red blood cells in the blood.
- Medications: Medications, such as erythropoietin, may be prescribed to stimulate the production of red blood cells in the bone marrow.
- Bone Marrow Transplant: A bone marrow transplant may be necessary to replace the damaged bone marrow with healthy bone marrow.
- Nutritional Supplements: Nutritional supplements, such as iron and vitamin B12, may be prescribed to treat any underlying nutritional deficiencies.
- Rest and Relaxation: Rest and relaxation may be necessary to help the body recover from any underlying illnesses or medications.
Pros and Cons of Treatment Options
| Treatment Option | Pros | Cons |
|---|---|---|
| Blood Transfusions | Quickly increases red blood cell count | Risk of blood-borne infections |
| Medications | Stimulates production of red blood cells | May have side effects, such as nausea and fatigue |
| Bone Marrow Transplant | Replaces damaged bone marrow with healthy bone marrow | High risk of complications, such as graft-versus-host disease |

What is a normal reticulocyte count?
+A normal reticulocyte count ranges from 0.5% to 1.5% of the total red blood cell count.
What are the symptoms of a low reticulocyte count?
+The symptoms of a low reticulocyte count include fatigue, weakness, shortness of breath, pale skin, and headaches.
How is a low reticulocyte count diagnosed?
+A low reticulocyte count is diagnosed through a blood test that measures the reticulocyte count and other blood cell counts.
What are the treatment options for a low reticulocyte count?
+The treatment options for a low reticulocyte count include blood transfusions, medications, bone marrow transplant, nutritional supplements, and rest and relaxation.